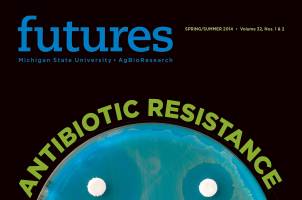

Antibiotic Resistance
Seeking solutions in a time of growing concern.
-
Line drawn on the farm: FDA calls for end of antibiotic use for animal growth promotion
Daniel Grooms is helping veterinarians and livestock producers gear up for the changes that the guidance document presents to the industry.
-
Warning issued over 50 years ago still rings true: CDC renews attention to antibiotic resistance
Labeled an urgent health threat in 2013, antibiotic resistance has become one of the world's greatest challenges. What is drug resistance and how does it develop?
-
Evolution in action: Long-term project stimulates research in many areas
The evolutionary process has never been directly observed for so many generations and in such details as in Richard Lenski's experiment on bacteria that now features more than 60,000 generations of E. coli.
-
The pressure is on: New ruling will end antibiotic use in organic fruit production
Fruit growers have long relied on a small amount of antibiotics to ward off one of the biggest threats. A new ruling will change that for some.
-
Antibiotic resistance: Tackling a tough, undeniably important topic
In this issue of Futures, we explore some of the research taking place at Michigan State University to help combat antibiotic resistance.
-
The good and the bad: Reconceptualizing bacteria and their roles in human health and disease
Linda Mansfield, MSU AgBioResearch microbiologist and veterinarian, is exploring the role of antibiotics in making humans more susceptible to infections caused by Campylobacter jejuni, a serious bacterial threat.
-
The driving force: Technological innovations accelerate environmental antibiotic resistance research
Technological advances have helped spur the frequently tedious and time-consuming efforts necessary to understand the complexity of drug resistance.
-
Dairy farms deliver: Antibiotic use on the decline while new alternatives remain on the uptick
Acting on the root cause of livestock diseases.
-
Priming the pipeline:The promising role of MSU in drug development
Several Michigan State University researchers are responding to the urgent call for new antibiotics and other novel drug therapies.

Print
Print Email
Email